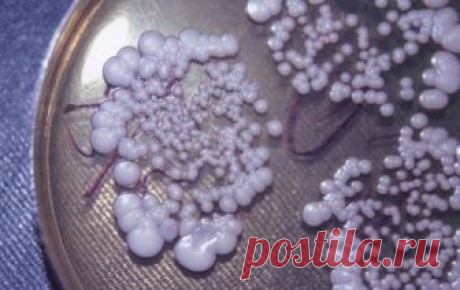

Кандидоз
budtezdorovy.net
Аюрведический метод лечения. Кандидоз Кандидоз (молочница) – заболевание, которое вызывают дрожжеподобные грибы рода Candida. Кандидоз не относится к половым инфекциям, поскольку его развитие не связано с половыми контактами. Заболевание обусловлено не просто наличием грибков (они могут присутствовать и в норме), а их интенсивным размножением. Кандидоз возникает при снижении общего и местного иммунитета. ...
polonsil.ru
Топ–10 лучших свечей от молочницы - ПолонСил.ру - социальная сеть здоровья - Медиаплатформа МирТесен С кандидозом, также известным как молочница, хотя бы раз в жизни сталкиваются 70–75% женщин, причем половина из них еще до 25 лет. Подготовили список лучших свечей от молочницы для женщин. Причиной молочницы являются грибы рода Candida, которые присутствуют в микрофлоре здорового влагалища в - 12 декабря - 43116671216 - Медиаплатформа МирТесен
sovet.rogovo101.ru
Микотический эзофагит: когда грибок поражает наш пищевод
Микозы органов пищеварения могут быть вызваны различными грибками. Однако чаще всего их поражают представители рода Candida, вызывая кандидоз. Грибы Candida — это одноклеточные диморфные микромицеты, которые в разных условиях образуют: — бластомицеты (они же клетки-почки); — или псевдомицелий (нити удлиненных клеток). И эта их особенность...
Читай дальше на сайте. Жми подробнее ➡
twoezdorove.ru
Как понять, что здоровье убивает грибок кандида? Симптомы и лечение кандидоза
Чрезмерное количество дрожжевых грибков в организме может привести к нарушению процесса пищеварения, появлению сыпи на коже, перхоти, проблем с памятью, депрессии и другим неблагоприятным последствиям. Переизбыток грибков чаще наблюдается у женщин. Почему так происходит? Согласно данным статистики половина женского...
Читай дальше на сайте. Жми подробнее ➡
fithacker.ru
Как понять, что здоровье убивает грибок кандида? Симптомы и лечение кандидоза Чрезмерное количество дрожжевых грибков в организме может привести к нарушению процесса пищеварения, появлению сыпи на коже, перхоти, проблем с памятью, депрессии и другим неблагоприятным последствиям. Переизбыток грибков чаще наблюдается у женщин. Почему так происходит?
women-jur.ru
Самая мощная трава, которая уничтожает стрептококк, герпес, кандидоз и грипп! - Женский Журнал Тимьян — один из самых популярных членов семьи мяты. Это трава родом из Средиземноморья, и люди там его называют «бульгари», сгреческого -духи. Тимьян обладает способностью уничтожать бактерии, уменьшать воспаление и успокаивать раздражение. Он обычно добавляется в продукты по уходу за кожей, и повара любят добавлять его в свои блюда. Тимьян разрушает стрептококк, герпес, кандидоз и …
kandiston.oficialshop.ru
Кандистон — средство №1 по борьбе с молочницей
Спрей от молочницы - Победа над кандидозом с первого применения!
- Устраняет зуд и жжение после первого нанесения
- Гарантирует выздоровление после 7 дней использования
- Не раздражает слизистую, оказывает успокаивающее и заживляющее действие
- Предотвращает рецидивы заболевания и его переход в хроническую форму
- Не оказывает побочных действий и не имеет противопоказаний.
- Гипоаллергенно, состоит из натуральных ингредиентов.
vrutmilife.com
Самая мощная трава, которая уничтожает стрептококк, герпес, кандидоз и грипп! Тимьян — один из самых популярных членов семьи мяты. Это трава родом из
Средиземноморья, и люди там его называют «бульгари», сгреческого -духи.
Тимьян обладает способностью уничтожать бактерии, уменьшать воспаление и успокаивать раздражение. Он обычно добавляется в продукты по уходу за кожей,
vrutmilife.com
Самая мощная трава, которая уничтожает стрептококк, герпес, кандидоз и грипп! Тимьян — один из самых популярных членов семьи мяты. Это трава родом из
Средиземноморья, и люди там его называют «бульгари», сгреческого -духи.
Тимьян обладает способностью уничтожать бактерии, уменьшать воспаление и успокаивать раздражение. Он обычно добавляется в продукты по уходу за кожей,